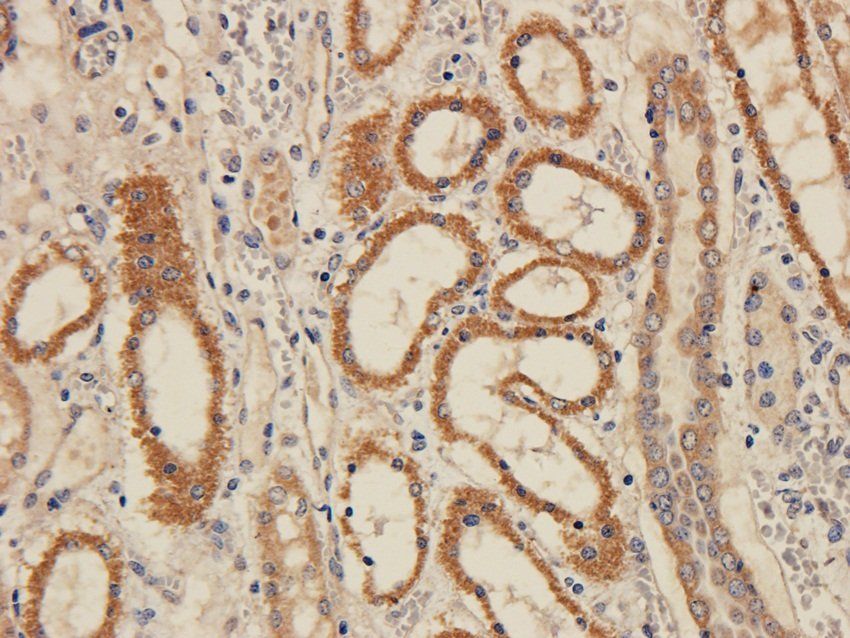
FPR1 Rabbit Polyclonal Antibody

You have no items in your shopping cart.
All Products
- Featured
CD38 Rabbit Polyclonal Antibody [orb10319]Featured
ICC, IF, IHC-P, WB
Guinea pig, Human, Mouse, Rat
Rabbit
Polyclonal
Unconjugated
100 μg - Featured
CD155 Rabbit Polyclonal Antibody [orb13359]Featured
IHC-P, WB
Human, Mouse, Rat
Rabbit
Polyclonal
Unconjugated
100 μg - Featured
FPR1 Rabbit Polyclonal Antibody [orb13410]Featured
ICC, IF, IHC-P, WB
Human, Mouse, Porcine, Rat
Rabbit
Polyclonal
Unconjugated
100 μg - Featured

- Featured
Syndecan 2 Rabbit Polyclonal Antibody [orb13481]Featured
ICC, IF, IHC-P, WB
Guinea pig, Human, Mouse, Rat
Bovine, Canine, Equine, Gallus, Porcine
Rabbit
Polyclonal
Unconjugated
100 μg - Featured
MCP3 Rabbit Polyclonal Antibody [orb256344]Featured
ELISA, ICC, IF, IHC-P
Human, Mouse, Porcine, Rat
Rabbit
Polyclonal
Unconjugated
100 μg - Featured
NKp44 Rabbit Polyclonal Antibody [orb315559]Featured
ELISA, IHC-P, WB
Human, Mouse, Rat
Rabbit
Polyclonal
Unconjugated
100 μg - RANKL Rabbit Polyclonal Antibody [orb315551]
ELISA, IHC-P
Human, Mouse, Rat
Rabbit
Polyclonal
Unconjugated
100 μg - Featured

- Featured
SDF1 Rabbit Polyclonal Antibody [orb251479]Featured
ELISA, ICC, IF, IHC-P, WB
Canine, Gallus, Human, Mouse, Rat
Rabbit
Polyclonal
Unconjugated
100 μg